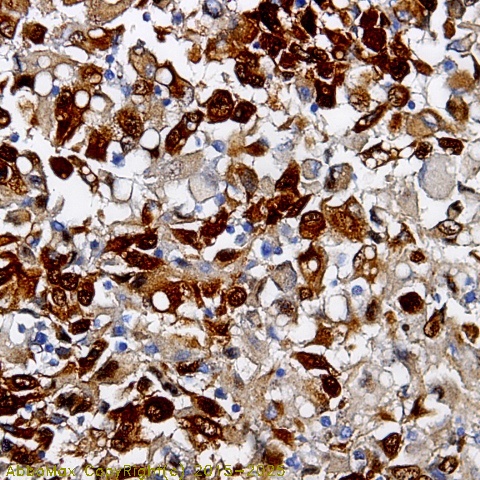

Desmin (pT76/77)
Desmin, Intermediate filament protein; CSM1, CSM2; CMD1l
 Download Product PDF
Download Product PDF
 MSDS Download Product PDF
MSDS Download Product PDF
Antigen Preparation
A synthetic peptide SRL G-*T-*T -RTP corresponding to the N-terminus with a dual phosphorylated threonine (Thr76/Thr77) of human Desmin.
Background
"Desmin is a major intermediate filament protein found exclusively in striated (skeletal or cardiac) muscle tissue. It belongs to a large family of class III intermediate filament protein, the main intermediate filamentin mature skeletal, cardiac and smooth muscle cells. Mutations in the gene encoding desmin are associated with desmin-related myopathy, a familial cardiac and skeletal myopathy (CSM), and with distal myopathies. PKC (Protein Kinase C) and cAMP-dependent protein kinase can induce disassembly of the desmin filaments by phosphorylating multiple sites at N-terminus of desmin which can affect the desmin filament structure which play a role in the regulatory process in assembly and turnover. "
PURIFICATION
The Rabbit IgG is purified by site-modified Epitope Affinity Purification.
|
SPECIFICITY
This antibody recognizes ~55 kDa of human Desmin protein at dual phosphorylated threonine (Thr76/Thr77). It does not recognize non-phosphorylated peptides confirmed by dot blot. The other species are not tested.
|
FORMULATION
This affinity purified antibody is supplied in sterile Tris-buffered saline (pH7.2) containing antibody stabilizer
|
STORAGE
The antibodies are stable for 24 months from date of receipt when stored at –20oC to –70oC. The antibodies can be stored at 2oC-8oC for three month without detectable loss of activity. Avoid repeated freezing-thawing cycles.
|
Applications/Suggested Working Dilutions
|
|
|
Immunoprecipitation
2-5 µg/ml
|
|
Flow cytometry
Not tested
|